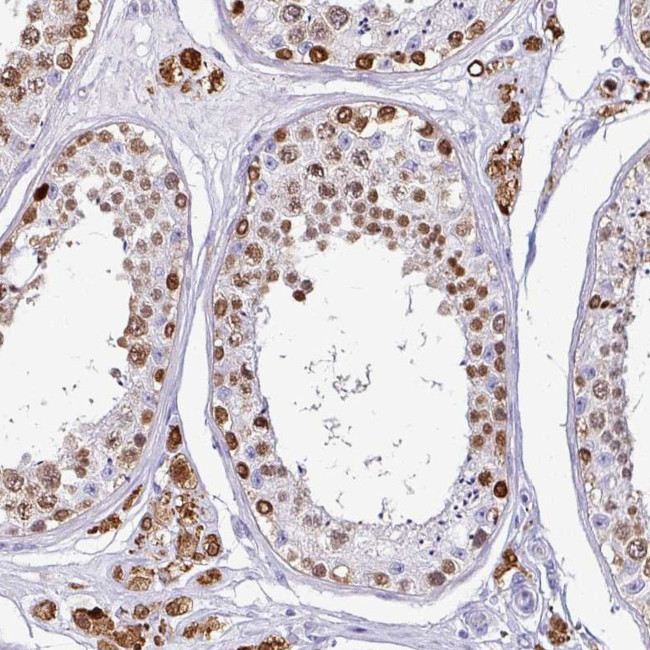
VCY1B Antibody in Immunohistochemistry (Paraffin) (IHC (P))

Search
Invitrogen
VCY1B Polyclonal Antibody
{{$productOrderCtrl.translations['antibody.pdp.commerceCard.promotion.promotions']}}
{{$productOrderCtrl.translations['antibody.pdp.commerceCard.promotion.viewpromo']}}
{{$productOrderCtrl.translations['antibody.pdp.commerceCard.promotion.promocode']}}: {{promo.promoCode}} {{promo.promoTitle}} {{promo.promoDescription}}. {{$productOrderCtrl.translations['antibody.pdp.commerceCard.promotion.learnmore']}}
产品信息
PA5-60888
种属反应
宿主/亚型
分类
类型
抗原
偶联物
形式
浓度
规格
纯化类型
保存液
内含物
保存条件
运输条件
RRID
产品详细信息
Immunogen sequence: AATKMAAVTA PEAESGPAAP GPSDQPSQE
Highest antigen sequence identity to the following orthologs: Mouse - 48%, Rat - 48%.
靶标信息
The protein encoded by this gene is a member of a family of human VCX/Y genes. This gene family has multiple members on both X and Y chromosomes, and all are expressed exclusively in male germ cells. Members of the VCX/Y family share a high degree of sequence identity, with the exception that a 30-bp unit is tandemly repeated in X-linked members but occurs only once in Y-linked members. VCX/Y genes encode small and highly charged proteins of unknown function. This gene encodes a small, positively charged protein. The presence of a putative bipartite nuclear localization signal suggests that this gene encodes a nuclear protein. The genome has two identical copies of this gene within a palindromic region; this record represents the more centromeric copy.
仅用于科研。不用于诊断过程。未经明确授权不得转售。
篇参考文献 (0)
生物信息学
蛋白别名: Basic charge, Y-linked 1; basic protein on Y chromosome, 1; small basic protein; testis-specific basic protein on Y, 1; Testis-specific basic protein Y 1; variable charge, Y chromosome; Variably charged protein Y
基因别名: BPY1; BPY1B; VCY; VCY1; VCY1A; VCY1B
UniProt ID: (Human) O14598
Entrez Gene ID: (Human) 9084